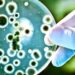
Helicobacter pylori, la bacteria silenciosa que puede causar desde gastritis hasta cáncer

Michelle Bachelet. (Suiza, Ginebra) EFE / EPA / TREZZINI MARCIAL
La expresidenta de Chile y ex alta comisionada de las Naciones Unidas para los Derechos Humanos, Michelle Bachelet, pidió este jueves “los mayores esfuerzos de los Gobiernos, las fuerzas políticas y la comunidad regional para lograr que la tendencia dictatorial y antihistórica no se consolide” en Venezuela, en una declaración conjunta que también suscriben 18 excancilleres latinoamericanos, varios exministros, embajadores y académicos que conforman en total una lista de 65 destacadas personalidades.
“La Mesa de Reflexión Latinoamericana, integrada por políticos, diplomáticos y académicos de diversos países de nuestra región, rechaza y declara como un grave error político, con irradiaciones a toda la región, la decisión adoptada por Venezuela de suspender las actividades la Oficina del Alto Comisionado de la ONU para los Derechos Humanos en ese país y expulsar a quienes trabajan allí“, señala el escrito, adelantado a EFE.
“Ese acto, unido a la detención de Rocío San Miguel, destacada experta en seguridad y defensora de los derechos humanos en Venezuela, configuran un panorama sombrío sobre el futuro de la democracia venezolana“, señala el manifiesto que suscriben también el expresidente de Bolivia Eduardo Rodríguez y los exministros de Relaciones Exteriores Rafael Bielsa (Argentina), Jorge Castañeda (México), Gustavo Fernández (Bolivia), Mariano Fernández (Chile), Diego García Sayán (Perú), José Ángel Gurría (México), Edgar Gutiérrez (Guatemala) y Enrique Iglesias (Uruguay).
También firman el manifiesto los excancilleres María Angela Holguín (Colombia), José Miguel Insulza (Chile), Grace Jaramillo (Ecuador), Celso Lafer (Brasil), Susana Malcorra (Argentina), María Emma Mejía (Colombia), Heraldo Muñoz (Chile), Javier Murillo (Bolivia), Felipe Solá (Argentina) y Allan Wagner (Perú), además del exministro de Hacienda de Colombia José Antonio Ocampo.
Lo que ocurre en Venezuela afecta a toda la región
“Para el resto de América Latina no es ajeno lo que ocurra en Venezuela, menos si ello enfrenta a Naciones Unidas y la plena vigencia de los derechos humanos. Hemos llegado a un año donde se aproxima una elección presidencial, pero la tendencia asumida por el Gobierno de Venezuela contra los opositores y críticos a sus políticas anticipan un nulo reconocimiento a los resultados de esa consulta electoral“, reza el manifiesto.
Los políticos, diplomáticos y académicos que forman la Mesa de Reflexión Latinoamericana -un mecanismo sin estructura permanente que en ocasiones se pronuncia sobre temas claves de la región- consideran que “el Gobierno del presidente (Nicolás) Maduro ha quebrado los compromisos acordados en Barbados entre el oficialismo y la oposición”, en alusión al inédito acuerdo suscrito en ese país caribeño a mediados de octubre pasado que en teoría permitiría unas elecciones libres en 2024.
“La democracia venezolana sólo recuperará el camino hacia una condición de respeto en el mundo si sus ciudadanos pueden entregar su voto en un escenario de plena vigencia de los derechos humanos y de libertades políticas donde la pluralidad sea efectiva“, recalca el escrito.
“Las carencias bajo las cuales vive el pueblo venezolano son evidentes (…), la alimentación es precaria y la pobreza se ha incrementado, mientras la migración de varios millones permea por varios países del hemisferio“, expresan los firmantes del manifiesto.
Además, llaman la atención sobre el hecho de que “los colaboradores del Alto Comisionado de la ONU sobre Derechos Humanos (cuyas actividades han sido suspendidas por el Gobierno de Nicolás Maduro) han estado allí para detectar la realidad y desde esas verdades contribuir a diseñar los planes del gobierno para superarlas“.
“Expulsarlos por hacer su tarea sólo expresa una miopía política y una obstinación autoritaria en mantener el poder, por encima de una mirada conjunta como nación sobre las mejores vías para salir de la crisis“, denuncian.
Por la gravedad de sus efectos para toda la región, “esta realidad no puede ser ajena a los países sudamericanos que constituyen el Consenso de Brasilia”, puesto en marcha en mayo 2023 y del cual forma parte también Venezuela, agrega el manifiesto.
Al respecto, los firmantes recuerdan que la hoja de ruta definida en octubre pasado por este mecanismo de concertación, cuyo objetivo es fortalecer los lazos entre los países de América del Sur, “reclama coherencia en la gobernabilidad y eficiencia de cada uno de los países miembros para cumplir sus objetivos“.
“Los recientes anuncios del Gobierno de Venezuela van en sentido contrario y esto reclama los mayores esfuerzos de los gobiernos, de las fuerzas política y la comunidad regional para lograr que esa tendencia dictatorial y antihistórica no se consolide“, recalca la declaración, cuyos firmantes aseguran que buscarán “contribuir tanto como sea posible en esa tarea“. EFE